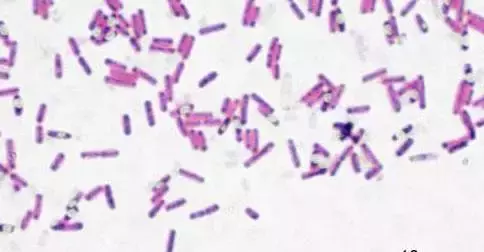
专业防水补漏，自动修复修楼房漏水！

专业防水补漏,专修楼房漏水!!!

我一直很好奇,这些面包车都是用什么材料防水补漏的。。是 SBS 改性沥青三元乙丙卷材氯丁橡胶建筑油膏水泥聚氨酯涂膜或者石棉网 cf-2000 高效复合防水剂还是有什么新型的材料?不过,如果用上了下面这个神奇的生物混凝土,再也不需要防水补漏了 — —

相比较于普通的混凝土,Bio Concrete 最大的特点就是 ——能自行修复
换句话说,家里的墙面地板用上这种生物混凝土,一旦出现裂缝,生物混凝土就会自动修复。神奇吧。。
生物混凝土,顾名思义,就是利用生物进行修复。

不过这种生物需要具备两种特性。。
第一,能够在极端的环境中长时间生存,而且前期要处于休眠状态,出现裂缝时再苏醒并进行修复。
第二,能够产生修复所需要的材料,主要就是石灰石。
而来自荷兰代尔夫特理工大学教授 Hendrik Jonkers 还真的发现了这样一种微生物 — —芽孢杆菌
这种细菌能在各种恶劣的环境下生存,即使在没有空气和食物的情况下也能生存几十年。而且芽孢杆菌在分解食物后刚好会产生修复所需要的石灰石。完美!!!

那具体要怎么实现呢?Hendrik Jonkers 首先将芽孢杆菌和乳酸钙放入可被分解的微型胶囊内。
然后将这些微型胶囊混入混凝土进行搅拌。
当墙体出现裂缝时,雨水会渗入裂缝。。
在雨水的作用下,微型胶囊内部处于休眠状态的芽孢杆菌会被激活,分解乳酸钙产生石灰石,并填补缝隙。
不知不觉中,墙壁的裂缝就莫名的自动修复了!!!

给墙体多喷喷水,还可以让裂缝愈合的更加完美。
防水补漏技术哪家强?Bio Concrete 生物混凝土放光芒!!!
版权声明:我们致力于保护作者版权,注重分享,被刊用文章【专业的防水补漏(专业防水补漏)】因无法核实真实出处,未能及时与作者取得联系,或有版权异议的,请联系管理员,我们会立即处理! 部分文章是来自自研大数据AI进行生成,内容摘自(百度百科,百度知道,头条百科,中国民法典,刑法,牛津词典,新华词典,汉语词典,国家院校,科普平台)等数据,内容仅供学习参考,不准确地方联系删除处理!;
工作时间:8:00-18:00
客服电话
电子邮件
beimuxi@protonmail.com
扫码二维码
获取最新动态
